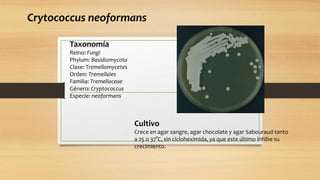

Cryptococcus
•Descargar como PPTX, PDF•
1 recomendación•1,549 vistas
caracteristicas de cryptococcus,
Denunciar
Compartir
Denunciar
Compartir
Más contenido relacionado
La actualidad más candente
La actualidad más candente (20)
Prueba IFAT (inmunofluorescencia directa e indirecta)

Prueba IFAT (inmunofluorescencia directa e indirecta)
Similar a Cryptococcus
Eritrasma, herpes simple, molusco contagioso y queratolisis plantar

Eritrasma, herpes simple, molusco contagioso y queratolisis plantarVoluntario Palacio Escuela de Medicina FacMed UNAM
Similar a Cryptococcus (20)
Clase 13 agentes etiologicos de dermatofitosis 2015

Clase 13 agentes etiologicos de dermatofitosis 2015
Eritrasma, herpes simple, molusco contagioso y queratolisis plantar

Eritrasma, herpes simple, molusco contagioso y queratolisis plantar
Último
Último (20)
OFICIAL TABIQUE DESVIADO presentacion de desviacion del tabique por sinusitis

OFICIAL TABIQUE DESVIADO presentacion de desviacion del tabique por sinusitis
FISIOLOGIA BACTERIANA y mecanismos de acción (1).pptx

FISIOLOGIA BACTERIANA y mecanismos de acción (1).pptx
SEGUNDA Y TERCERA SEMANA DEL DESARROLLO EMBRIONARIO.pptx

SEGUNDA Y TERCERA SEMANA DEL DESARROLLO EMBRIONARIO.pptx
Histologia del sistema respiratorio y sus funciones

Histologia del sistema respiratorio y sus funciones
patologia de robbins capitulo 4 Lesion celular.pdf

patologia de robbins capitulo 4 Lesion celular.pdf
(2024-04-29)Actualización en profilaxis PrEP frente a VIH. (DOC)

(2024-04-29)Actualización en profilaxis PrEP frente a VIH. (DOC)
Historia Clínica y Consentimiento Informado en Odontología

Historia Clínica y Consentimiento Informado en Odontología
Revista de psicología sobre el sistema nervioso.pdf

Revista de psicología sobre el sistema nervioso.pdf
Cryptococcus
- 1. Cultivo Crece en agar sangre, agar chocolate y agar Sabouraud tanto a 25 o 37°C, sin cicloheximida, ya que este último inhibe su crecimiento. Taxonomía Reino: Fungi Phylum: Basidiomycota Clase: Tremellomycetes Orden: Tremellales Familia: Tremellaceae Género: Cryptococcus Especie: neoformans Crytococcus neoformans
- 2. Crytococcus neoformans Morfología. Colonias son de color blanco amarillento a crema, y se tornan más oscuras al envejecer. Su aspecto es mucoide, poco elevadas, brillantes, de bordes enteros y húmedos.
- 3. Cryptococcus neoformans visto con Tinta China Características microscópicas Cryptococcus neoformans microscópicamente es una levadura redonda u ovoide de 4 a 6 µm de diámetro, que a menudo se encuentra en gemación. Se caracteriza por presentar una amplia cápsula de carbohidratos con un diámetro de hasta 25 µm o más.
- 4. Característica cápsula de una célula de C. neoformans gemando. Tinción negativa con tinta china de un aspirado ganglionar de un gato con criptococosis e infectado con el virus de la immunodeciencia felina.